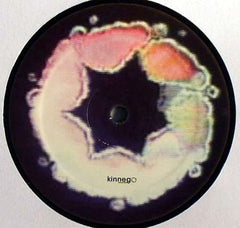
Boxcutter / Boxcutter & Kab Driver : Moon Pupils / 2Time (12")

Boxcutter / Boxcutter & Kab Driver - Moon Pupils / 2Time
A. Boxcutter - Moon Pupils
B. Boxcutter, Kab Driver - 2Time
Media Condition: Mint (M)
Sleeve Condition: Mint (M)
Cat Number: KGO003
Country: UK
Released: Oct 2010
Genre: Electronic
Style: IDM, UK Garage
Comments:
NEW / UNPLAYED
Notes:
p & c Kinnego Records 2010 Made in EU Manufactured and distributed by ST Holdings Ltd
Barcode and Other Identifiers:
Phonographic Copyright (p) Kinnego Records
Copyright (c) Kinnego Records
Manufactured For S.T. Holdings Ltd.
Distributed By S.T. Holdings Ltd.
Data provided by Discogs
Product listed via Disconnect
Some items are Pre-orders, I shall try my best to get the records for you. Use the contact page or text, to check availability.
UK:
FREE - Collect from the shop in Nottingham
£6.99 Second Class (Standard) + £2.00 Shipping for every additional item
£7.99 Second Class Recorded + £2.00 Shipping for every additional item
£7.99 First Class (Standard) + £2.00 Shipping for every additional item
£8.99 First Class Recorded + £2.00 Shipping for every additional item
Rest of the World:
£24.99 International Signed For Delivery + £5.00 every additional Item
Returns
If you're not happy with your items, return them unused within 7 days for a replacement or refund.
Terms and conditions
- If you're not happy with your items, return them unused within 7 days for a replacement or refund. We will try to accept all returns. It is important to us to keep you as a customer.
- For obvious reasons (e.g. piracy) we cannot accept unwanted/incorrect items that have been opened.
- Please make sure you pack your return securely.
- Always get proof of postage.
- If an item is returned to us in an unsuitable condition due to poor packaging then we may have to send it back to you without a refund.
- Buyer pays for the return shipping cost
